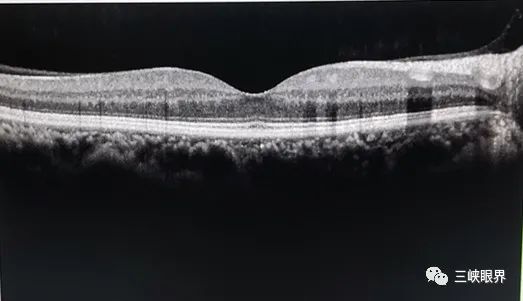
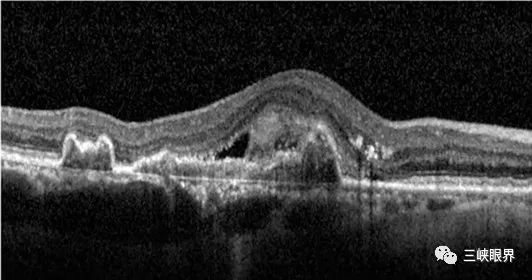

点击上方蓝字关注我吧

眼科小故事1
大家好,我是普普
 。为了更好的为大家科普眼科知识,了解眼科疾病,守护眼健康。今日起,我们开设了新的版块《眼科小故事》专辑。
今天我们的故事主人公,是一位65岁的退休老干部,王先生。
王先生今天早晨起床去公园晨练时,无意间发现左眼看东西视力下降,正前方总有一块黑影子遮挡。王先生吓了一跳,匆匆来到了眼科诊室。经过初步的问诊后,眼科医生给王先生开立了一项检查,黄斑OCT。
王先生:OCT?CT?为什么需要做CT呢。
医生:OCT并不是CT。您误会了,我们常说的OCT是光学相干断层扫描Optical Coherence Tomography的简称,许多病人总会误以为OCT也是CT,其实它是一种光学检查,和CT完全不同。
日常生活中,我们发现很多朋友都对这项检查非常陌生,实际上,这项检查可谓是我们眼科诊疗中的一把神器呢,那么接下来,我们就一起来了解一下,什么是OCT吧。
。为了更好的为大家科普眼科知识,了解眼科疾病,守护眼健康。今日起,我们开设了新的版块《眼科小故事》专辑。
今天我们的故事主人公,是一位65岁的退休老干部,王先生。
王先生今天早晨起床去公园晨练时,无意间发现左眼看东西视力下降,正前方总有一块黑影子遮挡。王先生吓了一跳,匆匆来到了眼科诊室。经过初步的问诊后,眼科医生给王先生开立了一项检查,黄斑OCT。
王先生:OCT?CT?为什么需要做CT呢。
医生:OCT并不是CT。您误会了,我们常说的OCT是光学相干断层扫描Optical Coherence Tomography的简称,许多病人总会误以为OCT也是CT,其实它是一种光学检查,和CT完全不同。
日常生活中,我们发现很多朋友都对这项检查非常陌生,实际上,这项检查可谓是我们眼科诊疗中的一把神器呢,那么接下来,我们就一起来了解一下,什么是OCT吧。
OCT:视网膜的解剖图





OCT,英文全称Optical Coherence Tomography,简称OCT,是一种高分辨率、非接触性的生物组织成像技术,跟我们常说的CT可完全不搭边哦!
它可以:清楚显示我们眼底视网膜每一层的结构。
OCT是继眼科放射、超声、眼底血管造影诊断后一项革命性的影像学诊断技术。

正常的黄斑OCT图片。

OCT检查怎么做

在过去的几十年里,非创伤性的眼科检查都只能“观其表”,对视网膜病变的诊断和理解全凭视网膜表面的蛛丝马迹来猜测,而OCT技术起到了颠覆性的作用,可以在毫无创伤的情况下,只需几分钟,视网膜病变来自哪一层都了解得清清楚楚。

您只需要将下巴搁在指定位置,在医生指导下注视特定注视点,保持约10-20秒即可,就像这样。

OCT检查有辐射吗?

无创、无辐射、老少皆宜
异常的OCT图片


黄斑裂孔
即:黄斑处裂开了一个孔洞,失去了正常的结构。而黄斑是我们视觉、色觉最重要的结构。因此,此病常常会出现视物扭曲变形、视野中心暗点等症状。
黄斑囊样水肿
黄斑囊样水肿是常见眼底病,就像发好的面团里面有很多孔一样。


什么时候需要做OCT

如果觉得自己的视力有所退化,尤其是有中心视力减退,暗点、视物变形等情况,想了解自己的黄斑是否健康,可至我院眼科门诊检查。(新城路165号重庆大学附属三峡医院眼科楼6楼)
如果发现问题请尽早就诊。
三峡中心医院眼底病专病门诊:周二、三上午;周一、四下午。眼科楼6楼。
回到主题,上面是王先生的OCT结果。眼底病专家分析后,初步判断是“老年性黄斑变性(AMD)”,建议王先生住院进一步治疗。
那么,什么是AMD呢?我们将在下期内容中详细为大家介绍哦。
回到主题,上面是王先生的OCT结果。眼底病专家分析后,初步判断是“老年性黄斑变性(AMD)”,建议王先生住院进一步治疗。
那么,什么是AMD呢?我们将在下期内容中详细为大家介绍哦。
 专家介绍
专家介绍
 彭日波,硕士研究生,2014年毕业于西南医科大学眼科专业,在国内外核心期刊发表核心论文3篇。专业特长:各种角膜炎、青光眼、白内障、眼底视网膜疾病,对眼科常见病及多发病、疑难杂症的诊断及治疗有丰富的临床经验。2019年6月-11月前往重医附一院学习玻璃体切除手术,能独立开展眼底手术
。
彭日波,硕士研究生,2014年毕业于西南医科大学眼科专业,在国内外核心期刊发表核心论文3篇。专业特长:各种角膜炎、青光眼、白内障、眼底视网膜疾病,对眼科常见病及多发病、疑难杂症的诊断及治疗有丰富的临床经验。2019年6月-11月前往重医附一院学习玻璃体切除手术,能独立开展眼底手术
。



祝毅,硕士研究生,2013年毕业于重庆医科大学眼科学。2019年9月-2020年2月前往四川大学华西医院学习玻璃体切除手术。
专业特长:对眼科常见疾病及多发病的诊治有丰富的临床经验、包括各种各种角膜炎、青光眼、白内障、眼底视网膜疾病等。
并擅长眼底激光及玻璃体视网膜等手术,能独立开展眼底手术。



END
文稿 | 李娜 腾嵘
编辑 | 李娜
审核 | 杨晓春 刘雁
(文章内图片来自网络,侵删)
重庆大学附属三峡医院眼科
023-58103168


点在看,让更多看见。







 OCT(光学相干断层扫描)是一种无创、无辐射的高分辨率成像技术,能清晰展示视网膜各层结构。通过OCT检查,医生能快速准确判断视网膜病变的位置,如黄斑裂孔和囊样水肿。当出现视力退化、中央视力下降、视物扭曲等症状时,可以考虑进行OCT检查。
OCT(光学相干断层扫描)是一种无创、无辐射的高分辨率成像技术,能清晰展示视网膜各层结构。通过OCT检查,医生能快速准确判断视网膜病变的位置,如黄斑裂孔和囊样水肿。当出现视力退化、中央视力下降、视物扭曲等症状时,可以考虑进行OCT检查。
















 5001
5001

 被折叠的 条评论
为什么被折叠?
被折叠的 条评论
为什么被折叠?








